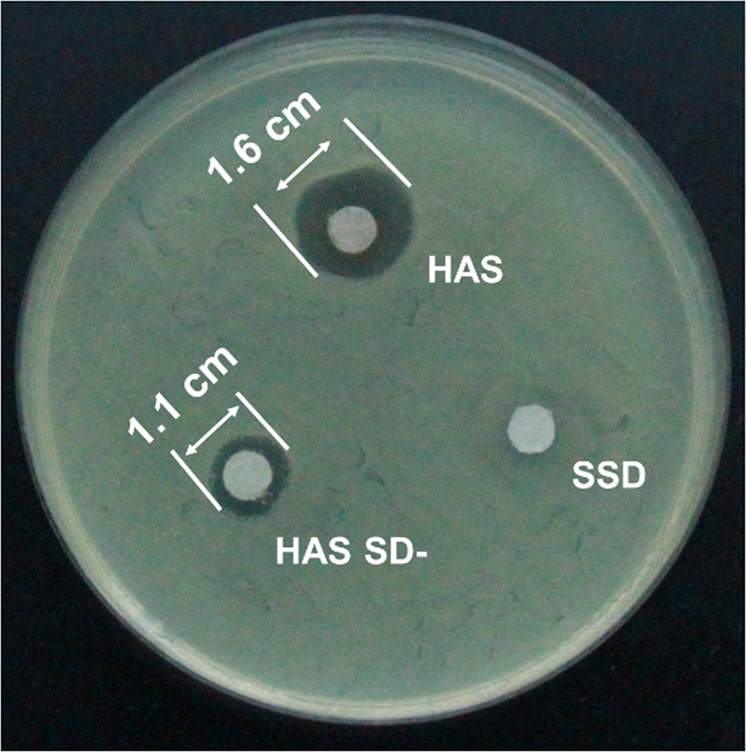
Fig. 9

Fig. 9: Antibacterial activity of HAS by the disk-diffusion method.
From: Triple-synergistic 2D material-based dual-delivery antibiotic platform

E. coli with HAS, HAS SD- and SSD.
From: Triple-synergistic 2D material-based dual-delivery antibiotic platform
E. coli with HAS, HAS SD- and SSD.